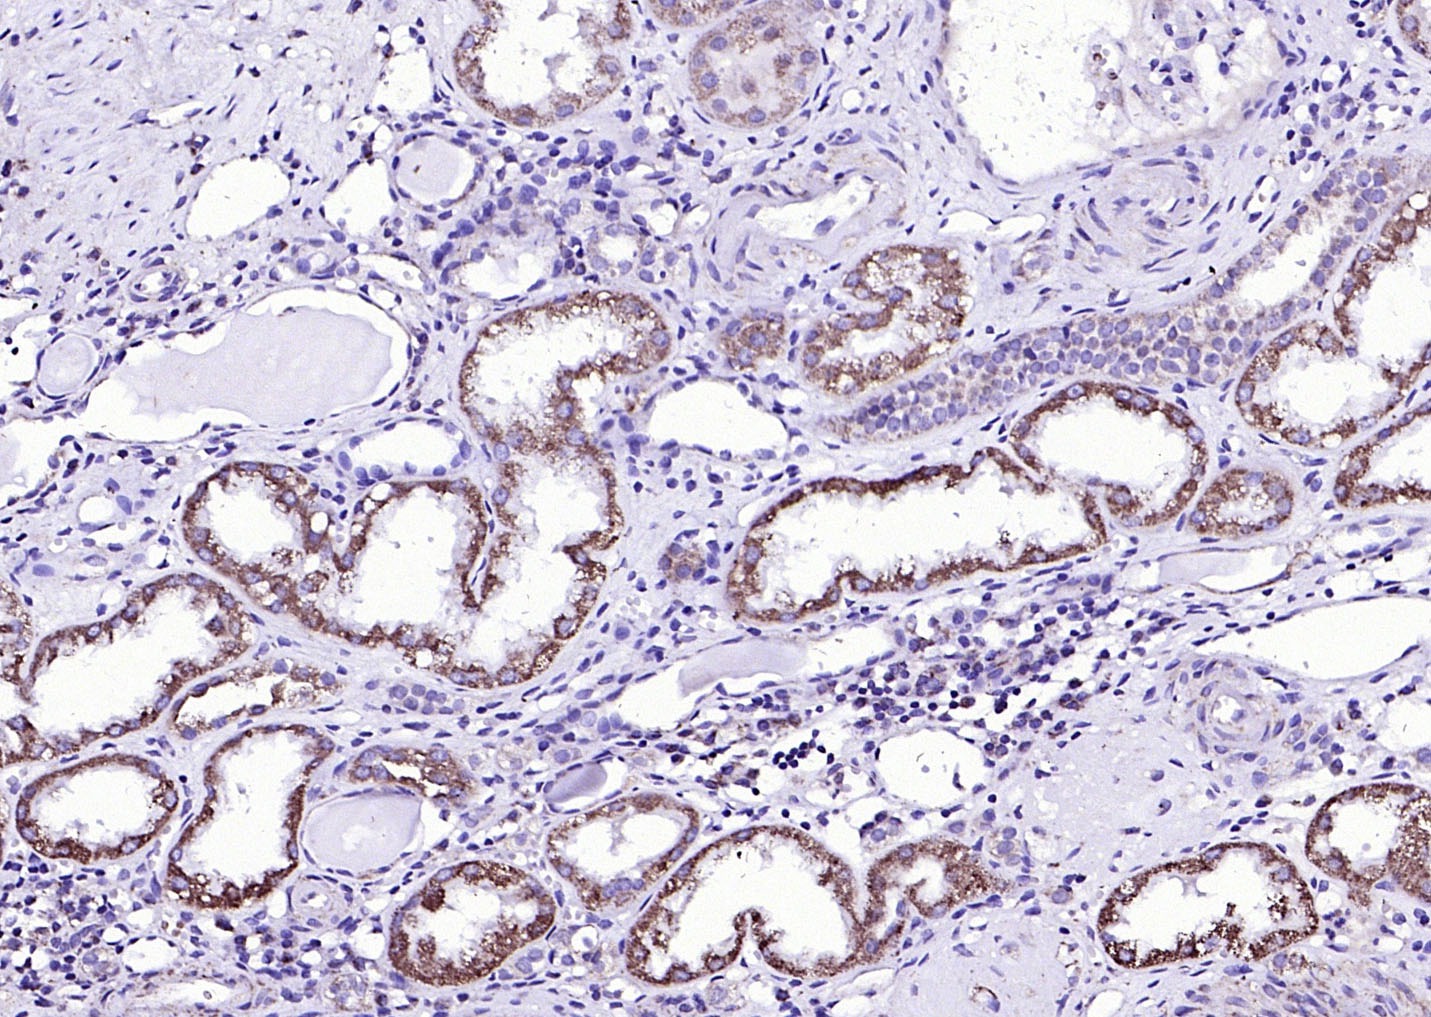
verifiedActivity

购物车
 您的购物车当前为空
您的购物车当前为空
Anti-ACVR2B Polyclonal Antibody 是一种 Rabbit 抗体,靶向 ACVR2B。Anti-ACVR2B Polyclonal Antibody 可用于 IF, IHC-Fr, IHC-P, WB。
别名 HTX4, ActR-IIB, ACTRIIB, Activin RIIB, activin A receptor, type IIB
Anti-ACVR2B Polyclonal Antibody 是一种 Rabbit 抗体,靶向 ACVR2B。Anti-ACVR2B Polyclonal Antibody 可用于 IF, IHC-Fr, IHC-P, WB。
| 规格 | 价格 | 库存 | 数量 |
|---|---|---|---|
| 50 μL | ¥ 1,160 | 5日内发货 | |
| 100 μL | ¥ 1,965 | 5日内发货 | |
| 200 μL | ¥ 2,785 | 5日内发货 |
TargetMol的所有产品仅用作科学研究或药证申报,不能被用于人体,我们不向个人提供产品和服务。请您遵守承诺用途,不得违反法律法规规定用于任何其他用途。
| 产品描述 | Anti-ACVR2B Polyclonal Antibody is a Rabbit antibody targeting ACVR2B. Anti-ACVR2B Polyclonal Antibody can be used in IF, IHC-Fr, IHC-P, WB. |
| 别名 | HTX4, ActR-IIB, ACTRIIB, Activin RIIB, activin A receptor, type IIB |
| Ig Type | IgG |
| 反应种属 | Human,Mouse (predicted:Rat,Dog,Pig,Cow,Sheep) |
| 验证活性 | 1. Paraformaldehyde-fixed, paraffin embedded (Human kidney); Antigen retrieval by boiling in sodium citrate buffer (pH6.0) for 15 min; Block endogenous peroxidase by 3% hydrogen peroxide for 20 min; Blocking buffer (normal goat serum) at 37°C for 30 min; Antibody incubation with (Activin Receptor Type IIB) Polyclonal Antibody, Unconjugated (TMAB-00052) at 1:200 overnight at 4°C, followed by operating according to SP Kit (Rabbit) instructionsand DAB staining. 2. Sample: K562 (Human) Cell Lysate at 30 μg 293t (Human) Cell Lysate at 30 μg Primary: Anti-Activin Receptor Type IIB (TMAB-00052) at 1/1000 dilution Secondary: IRDye800CW Goat Anti-Rabbit IgG at 1/20000 dilution Predicted band size: 56 kDa Observed band size: 56 kDa 3. Sample: Lane 1: Mouse Heart tissue lysates Lane 2: Mouse Muscle tissue lysates Lane 3: Mouse Testis tissue lysates Lane 4: Mouse Kidney tissue lysates Lane 5: Human K562 cell lysates Lane 6: Human SH-SY5Y cell lysates Lane 7: Human Jurkat cell lysates Lane 8: Human MOLT4 cell lysates Primary: Anti-Activin Receptor Type IIB (TMAB-00052) at 1/1000 dilution Secondary: IRDye800CW Goat Anti-Rabbit IgG at 1/20000 dilution Predicted band size: 56 kDa Observed band size: 60 kDa |
| 应用 | IFIHC-FrIHC-PWB |
| 推荐剂量 | WB: 1:500-2000; IHC-P: 1:100-500; IHC-Fr: 1:100-500; IF: 1:100-500 |
| 抗体种类 | Polyclonal |
| 宿主来源 | Rabbit |
| 亚细胞定位 | Cell membrane; Single-pass type I membrane protein. |
| 构建方式 | Polyclonal Antibody |
| 纯化方式 | Protein A purified |
| 性状 | Liquid |
| 缓冲液 | 0.01M TBS (pH7.4) with 1% BSA, 0.02% Proclin300 and 50% Glycerol. |
| 浓度 | 1 mg/mL |
| 研究背景 | Activin receptor type-2B( Activin receptor type IIB; ACTR-IIB ) On ligand binding, forms a receptor complex consisting of two type II and two type I transmembrane serine/threonine kinases. Type II receptors phosphorylate and activate type I receptors which autophosphorylate, then bind and activate SMAD transcriptional regulators. Receptor for activin A, activin B and inhibin A. [Subcellular Location] Membrane; Single-pass type I membrane protein. Belongs to the protein kinase superfamily. TKL Ser/Thr protein kinase family. TGFB receptor subfamily. |
| 免疫原 | KLH conjugated synthetic peptide: human ACVR2B/ACTR-IIB |
| 抗原种属 | Human |
| 基因名称 | ACVR2B |
| 基因ID | |
| 蛋白名称 | Activin receptor type-2B |
| Uniprot ID | |
| 研究领域 | Actin Binding Proteins,Other Kinases,Surface Molecules |
| 功能 | Transmembrane serine/threonine kinase activin type-2 receptor forming an activin receptor complex with activin type-1 serine/threonine kinase receptors (ACVR1, ACVR1B or ACVR1c). Transduces the activin signal from the cell surface to the cytoplasm and is thus regulating many physiological and pathological processes including neuronal differentiation and neuronal survival, hair follicle development and cycling, FSH production by the pituitary gland, wound healing, extracellular matrix production, immunosuppression and carcinogenesis. Activin is also thought to have a paracrine or autocrine role in follicular development in the ovary. Within the receptor complex, the type-2 receptors act as a primary activin receptors (binds activin-A/INHBA, activin-B/INHBB as well as inhibin-A/INHA-INHBA). The type-1 receptors like ACVR1B act as downstream transducers of activin signals. Activin binds to type-2 receptor at the plasma membrane and activates its serine-threonine kinase. The activated receptor type-2 then phosphorylates and activates the type-1 receptor. Once activated, the type-1 receptor binds and phosphorylates the SMAD proteins SMAD2 and SMAD3, on serine residues of the C-terminal tail. Soon after their association with the activin receptor and subsequent phosphorylation, SMAD2 and SMAD3 are released into the cytoplasm where they interact with the common partner SMAD4. This SMAD complex translocates into the nucleus where it mediates activin-induced transcription. Inhibitory SMAD7, which is recruited to ACVR1B through FKBP1A, can prevent the association of SMAD2 and SMAD3 with the activin receptor complex, thereby blocking the activin signal. Activin signal transduction is also antagonized by the binding to the receptor of inhibin-B via the IGSF1 inhibin coreceptor. |
| 分子量 | Theoretical: 56 kDa. Actual: 60 kDa. |
| 储存方式 | Store at -20°C or -80°C for 12 months. Avoid repeated freeze-thaw cycles. |
| 运输方式 | Shipping with blue ice. |